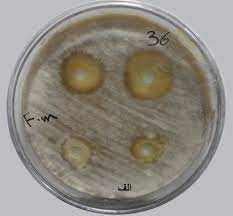

اِیمی مالینز(Aimee Mullins): دویدن
۶ آبان ۱۳۹۷در این ویدئوی آرشیویِ TED از سال ۱۹۹۸، قهرمان دوی سرعت پارا المپیک، ایمی مالینز، در مورد شکستن رکورد در حرفۀ خودش (دویدن) و این که چطور پاهای مصنوعی عجیبش از جنس الیاف کربن (که آن موقع فقط نمونه آزمایشی بودند) کمکش کردند تا از خط پایان بگذرد، صحبت می کند.
نوشتههای مرتبط:
استفان سگمیستر طراح گرافیک با لحظات شاد زندگی اش ما را به یک سفر عجیب می برد و توجه کنید که این لحظات شاد چگونه از طریق طراحی ایجاد شده اند.
سردبیر بخش سلامت رویترز، ایوان اورانسکی هشدار می دهد که ما از یک اپیدمی پیششرط های نامعقول رنج می بریم (مانند دیابت بالقوه، سرطان بالقوه، و بسیاری دیگر). در این بحث جذاب از او نشان می دهد که چگونه بهداشت و درمان می توانند با صحبت دربارهی درس مهمی که از بیس بال می گیریم، …
باری شوارتز در خطابه ای آتشین و پرحرارت از حکمت عملی به عنوان پادزهری برای جامعه ای که بوروکراسی آن را به مرز جنون کشانده است، سخن می راند. او با قدرت استدلال می کند که قوانین اغلب باعث درماندگی ما می شوند، انگیزه ها اغلب نتیجه معکوس می گیرند و حکمت عملی و امروزی …

0 دیدگاه برای “اِیمی مالینز(Aimee Mullins): دویدن”
دیدگاهی برای این مطلب نوشته نشده است.